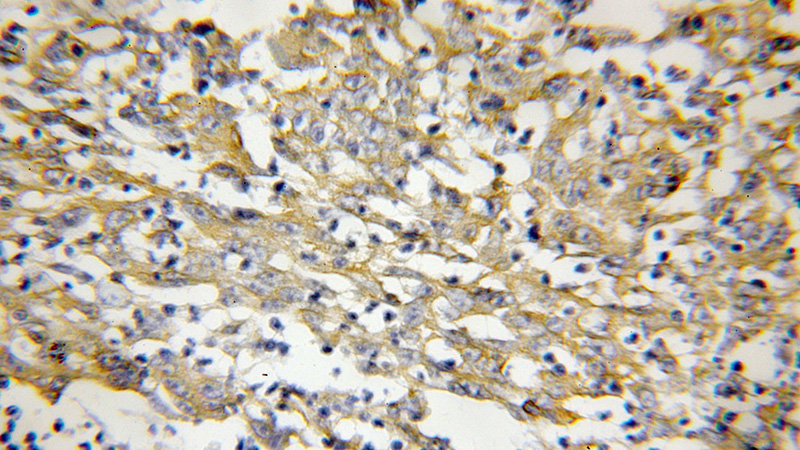
Immunohistochemical of paraffin-embedded human colon cancer using Catalog No:110669(FKBP10 antibody) at dilution of 1:50 (under 10x lens)

-
Product Name
FKBP10 antibody
- Documents
-
Description
FKBP10 Rabbit Polyclonal antibody. Positive IHC detected in human colon cancer tissue. Positive IF detected in HEK-293 cells. Positive IP detected in HEK-293 cells. Positive WB detected in HEK-293 cells, fetal human brain tissue, human brain tissue, human kidney tissue, human placenta tissue, NIH/3T3 cells. Observed molecular weight by Western-blot: 64 kDa
-
Tested applications
ELISA, IHC, WB, IP, IF
-
Species reactivity
Human,Mouse,Rat; other species not tested.
-
Alternative names
65 kDa FK506 binding protein antibody; 65 kDa FKBP antibody; FK506 binding protein 10 antibody; FKBP 10 antibody; FKBP 65 antibody; FKBP10 antibody; FKBP6 antibody; FKBP65 antibody; FLJ20683 antibody; FLJ22041 antibody; FLJ23833 antibody; hFKBP65 antibody; Immunophilin FKBP65 antibody; PPIase FKBP10 antibody; Rotamase antibody
-
Isotype
Rabbit IgG
-
Preparation
This antibody was obtained by immunization of FKBP10 recombinant protein (Accession Number: NM_021939). Purification method: Antigen affinity purified.
-
Clonality
Polyclonal
-
Formulation
PBS with 0.1% sodium azide and 50% glycerol pH 7.3.
-
Storage instructions
Store at -20℃. DO NOT ALIQUOT
-
Applications
Recommended Dilution:
WB: 1:200-1:2000
IP: 1:200-1:2000
IHC: 1:20-1:200
IF: 1:50-1:500
-
Validations

HEK-293 cells were subjected to SDS PAGE followed by western blot with Catalog No:110669(FKBP10 Antibody) at dilution of 1:600
Immunohistochemical of paraffin-embedded human colon cancer using Catalog No:110669(FKBP10 antibody) at dilution of 1:50 (under 10x lens)

Immunofluorescent analysis of (10% Formaldehyde) fixed HEK-293 cells using Catalog No:110669(FKBP10 Antibody) at dilution of 1:50 and Alexa Fluor 488-congugated AffiniPure Goat Anti-Rabbit IgG(H+L)

IP Result of anti-FKBP10 (IP:Catalog No:110669, 4ug; Detection:Catalog No:110669 1:600) with HEK-293 cells lysate 2800ug.
-
Background
FKBP10 represents FK506 binding protein 10, 65 kDa
-
References
- Murphy LA, Ramirez EA, Trinh VT, Herman AM, Anderson VC, Brewster JL. Endoplasmic reticulum stress or mutation of an EF-hand Ca(2+)-binding domain directs the FKBP65 rotamase to an ERAD-based proteolysis. Cell stress & chaperones. 16(6):607-19. 2011.
- Lietman CD, Rajagopal A, Homan EP. Connective tissue alterations in Fkbp10-/- mice. Human molecular genetics. 23(18):4822-31. 2014.
- Duran I, Nevarez L, Sarukhanov A. HSP47 and FKBP65 cooperate in the synthesis of type I procollagen. Human molecular genetics. 24(7):1918-28. 2015.
- Hung V, Zou P, Rhee HW. Proteomic mapping of the human mitochondrial intermembrane space in live cells via ratiometric APEX tagging. Molecular cell. 55(2):332-41. 2014.
Related Products / Services
Please note: All products are "FOR RESEARCH USE ONLY AND ARE NOT INTENDED FOR DIAGNOSTIC OR THERAPEUTIC USE"
